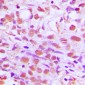

- 产品
- 定制服务
ELITE™ 定制服务抗药物抗体(Anti-Drug Antibodies,ADAs)制备抗宿主细胞蛋白(HCP)抗体制备IVD原料定制多肽合成蛋白表达重组抗体制备免疫检测服务抗体测序分子生物学服务常见问题解答如您对以上ELITE™定制服务有疑问,可以参考此版,这里汇聚了最常见的定制服务问题和解答供您参考。
如果您的疑问仍未解决,
请联系:tech-china@abcepta.com
我们为您提供博士级技术支持服务。
- 支持
- 订购
 产品订购我司在中国大陆采取由代理商分销的方式,不直接销售给终端科研用户,但我们可以在线接收您的产品订单。点此查看:中国授权代理商
产品订购我司在中国大陆采取由代理商分销的方式,不直接销售给终端科研用户,但我们可以在线接收您的产品订单。点此查看:中国授权代理商
定制服务请来电咨询:0512-88856768,也可发送邮件至:orders-china@abcepta.com - 我们
公司简介ABCEPTA(百远生物)目前已自主生产20,000多种高品质目录抗体。ABCEPTA在美中两地分别设有运营实体公司,为广大科研用户提供高品质抗体及相关生物试剂产品和博士级技术支持,同时提供抗药物抗体定制、抗宿主细胞蛋白抗体定制、多克隆抗体定制、单克隆抗体定制、单抗测序、重组蛋白表达、重组抗体表达等相关抗体定制服务,已成功服务全球10000余名科研和工业客户。


- 活动

- 工具
工具癌症通路交叉网络分析工具
 癌症的基本特征包括细胞增殖、血管生成、迁移、凋亡逃避机制和细胞永生等。找到癌症发生过程中这些通路的关键标记物和对应的抗体用于检测至关重要。
癌症的基本特征包括细胞增殖、血管生成、迁移、凋亡逃避机制和细胞永生等。找到癌症发生过程中这些通路的关键标记物和对应的抗体用于检测至关重要。
我们为您提供一个神器——癌症通路交叉网络分析工具,助力您的科研。SUMOplot™分析工具 为您推荐一个泛素化位点预测神器——泛素化分析工具,可以为您的蛋白的泛素化位点作出预测和评分。
为您推荐一个泛素化位点预测神器——泛素化分析工具,可以为您的蛋白的泛素化位点作出预测和评分。
泛素化修饰存在各种细胞过程中后翻译修饰中,比如细胞核-细胞质中的运输、常规转录、细胞凋亡、蛋白质稳定性、对压力的反应,乃至贯穿于整个细胞循环过程中。细胞自噬受体图形绘图工具 细胞自噬受体图形绘图工具为你的蛋白的细胞受体结合位点作出预测和评分,识别结合到自噬通路中的蛋白是非常重要的,便于让我们理解自噬在正常生理、病理过程中的作用,如发育、细胞分化、神经退化性疾病、压力条件下、感染和癌症。
细胞自噬受体图形绘图工具为你的蛋白的细胞受体结合位点作出预测和评分,识别结合到自噬通路中的蛋白是非常重要的,便于让我们理解自噬在正常生理、病理过程中的作用,如发育、细胞分化、神经退化性疾病、压力条件下、感染和癌症。
- 文献引用
- 免疫组化专题